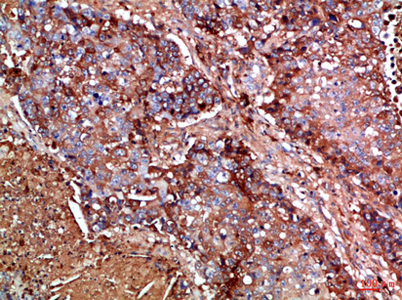
Immunohistochemical analysis of paraffin-embedded Human-lung-cancer, antibody was diluted at 1:100 Immunohistochemical analysis of paraffin-embedded Human-lung-cancer, antibody was diluted at 1:100

Haptoglobin Rabbit pAb
Product Code:
ELK-ES8771
ELK-ES8771
Host Type:
Rabbit
Rabbit
Antibody Clonality:
Polyclonal
Polyclonal
Regulatory Status:
RUO
RUO
Target Species:
Human
Human
Applications:
- Enzyme-Linked Immunosorbent Assay (ELISA)
- Immunohistochemistry- Paraffin Embedded (IHC-P)
No additional charges, what you see is what you pay! *
| Code | Size | Price |
|---|
| ELK-ES8771-20ul | 20ul | £100.00 |
| ELK-ES8771-50ul | 50ul | £156.00 |
| ELK-ES8771-100ul | 100ul | £221.00 |
Prices exclude any Taxes / VAT